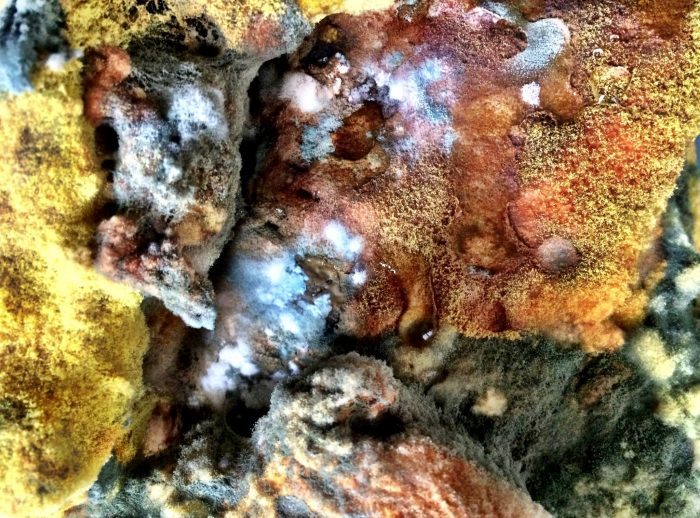

-

Stone drippingPicture on Plexiglass70 x 50 cm. -

Meeting on the beachPicture on Plexiglass70 x 50 cm. -

Over the TopPicture on Plexiglass70 x 50 cm. -

Landscape in Picture on Plexiglass70 x 50 cm. -

Roman FiresPicture on plexiglass70 x 50 cm. -

Growing DesertPicture on Plexiglass70 x 50 cm. -

Very French LandscapePicture on Plexiglass70 x 50 cm. -

Peeping throughPicture on plexiglass70 x 50 cm. -

AttackedPicture on plexiglass50 x 70 cm. -

AquaplaningPicture on plexiglass70 x 50 cm. -

Sun is up!Picture on Plexiglass70 x 50 cm. -

Chalk Landscape (2020)Picture on plexiglass50 x 70 cm. -

Dressing AtmospherePicture on Plexiglass50 x 70 cm. -

Threatening WallPicture on Plexiglass70 x 50 cm. -

After the WarPicture on plexiglass70x50cm. -

Christmas Scenery Picture on plexiglass70×50 cm. -

Pleated hillsPicture on plexiglass70 x 50 cm. -

Screening perspectivePicture on plexiglass50 x 70 cm. -

FirewallPicture on plexiglass 70 x 50 cm.

Stone drippingPicture on Plexiglass70 x 50 cm. 
Meeting on the beachPicture on Plexiglass70 x 50 cm. 
Over the TopPicture on Plexiglass70 x 50 cm. 
Landscape in Picture on Plexiglass70 x 50 cm. 
Roman FiresPicture on plexiglass70 x 50 cm. 
Growing DesertPicture on Plexiglass70 x 50 cm. 
Very French LandscapePicture on Plexiglass70 x 50 cm. 
Peeping throughPicture on plexiglass70 x 50 cm. 
AttackedPicture on plexiglass50 x 70 cm. 
AquaplaningPicture on plexiglass70 x 50 cm. 
Sun is up!Picture on Plexiglass70 x 50 cm. 
Chalk Landscape (2020)Picture on plexiglass50 x 70 cm. 
Dressing AtmospherePicture on Plexiglass50 x 70 cm. 
Threatening WallPicture on Plexiglass70 x 50 cm. 
After the WarPicture on plexiglass70x50cm. 
Christmas Scenery Picture on plexiglass70×50 cm. 
Pleated hillsPicture on plexiglass70 x 50 cm. 
Screening perspectivePicture on plexiglass50 x 70 cm. 
FirewallPicture on plexiglass 70 x 50 cm.